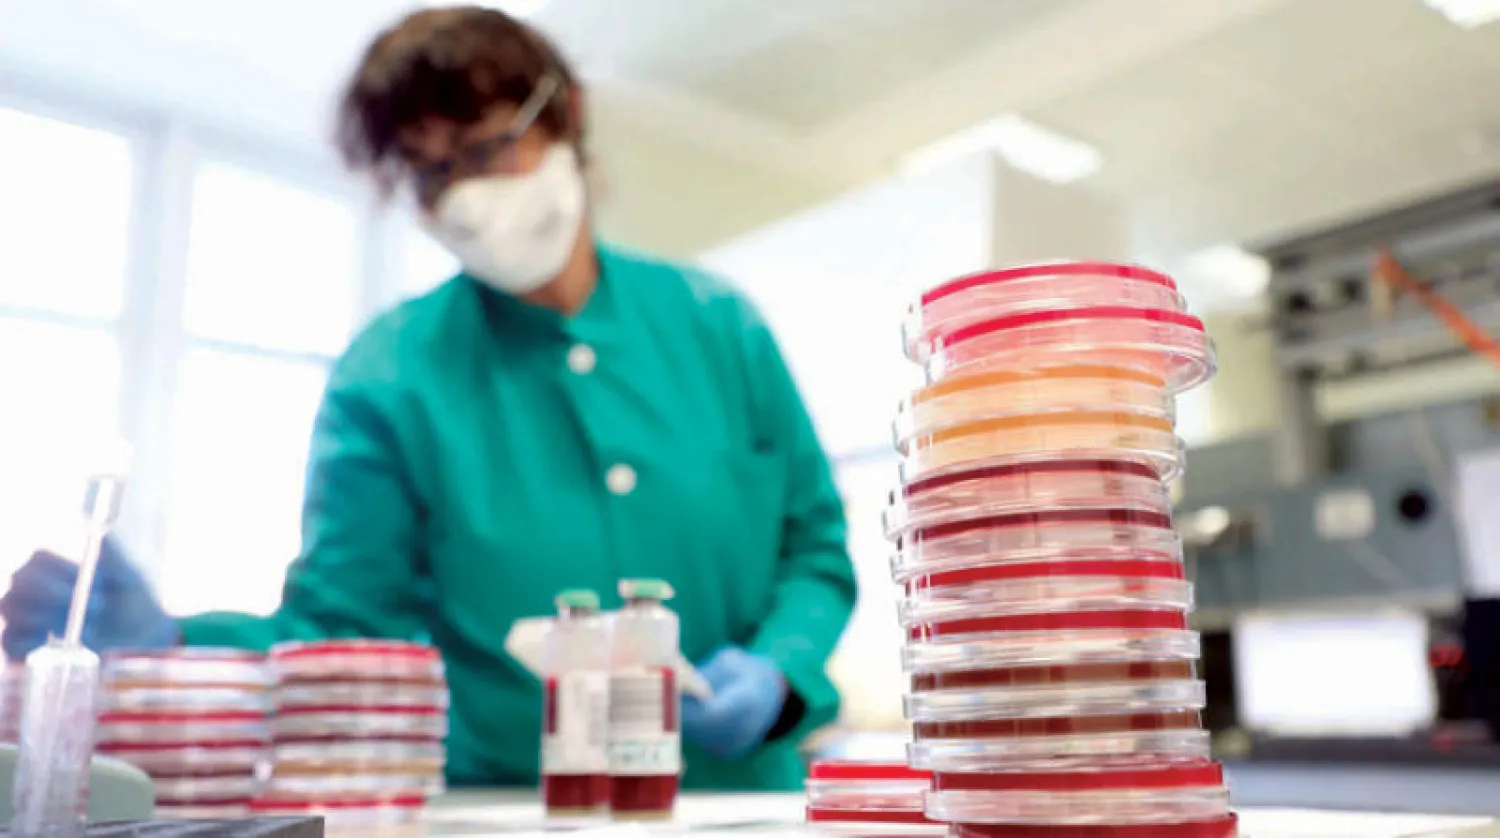
باحث داخل معمل للأحياء الدقيقة وعلوم الفيروسات في ميلانو بإيطاليا (إ.ب.أ)

ذكرت وكالة «بلومبرغ» الأميركية، أن اتفاق الصين التجاري مع الولايات المتحدة قد يصبح مهددا، في ظل انتشار فيروس «كورونا» الجديد، الذي ضرب البلاد مطلع شهر يناير (كانون الثاني) الجاري، مسببا هزة اقتصادية لثاني اقتصادات العالم ربما تقوض قدرتها على الوفاء بالتزاماتها بمضاعفة مشترياتها من المنتجات الزراعية الأميركية، حسبما نص الاتفاق المبدئي.
وأوضحت «بلومبرغ» أمس أن الوعود التي قطعتها بكين بشأن شراء المزيد من السلع الأميركية، والتي وصفت بـ«غير المنطقية» من جانب الخبراء، بات من الصعب تنفيذها في ضوء تداعيات الفيروس السلبية على الداخل الصيني مع ضعف الطلب المحلي واضطراب سلاسل التوريد الكبرى.
وأشارت إلى أن المرحلة الأولى من الاتفاق التجاري بين واشنطن وبكين المقرر أن يدخل حيز التنفيذ منتصف فبراير (شباط) المقبل، تلزم الجانب الصيني بمضاعفة مشترياته من السلع الأميركية بنحو 76.7 مليار دولار بشكل مبدئي، ثم 123 مليار دولار إضافية خلال العام المقبل.
وأضافت أنه مع سرعة انتشار الفيروس المستجد في الصين وارتفاع الوفيات، تتحول الأنظار صوب المادة رقم 7 من الاتفاق المبدئي، والتي تنص على ضرورة أن يتشاور الجانبان الأميركي والصيني حال حدوث كارثة طبيعية أو وقوع حدث طارئ قد يمنع أيا منهما عن الوفاء بالتزاماته.
ونقلت «بلومبرغ» عن وزير الزراعة الأميركي سوني بيردو، القول: «بات واضحا أن الفيروس الجديد سيخلف تداعيات سلبية على الاقتصاد الصيني، ولذلك نأمل ألا يعيق ذلك قدرة بكين على الوفاء بشراء المنتجات الأميركية المقررة لهذا العام».
ويركز الاقتصادان الكبيران على مستوى العالم جهودهما على اتخاذ كافة التدابير اللازمة لمنع انتشار المرض، حيث أكد المتحدث باسم البيت الأبيض أن بلاده تتعاون مع الصين بشكل وثيق بشأن الفيروس وحماية الصحة العامة للبلدين.
وتخيم تداعيات الأزمة على الاقتصاد الصيني بقوة. وقال اقتصادي بالحكومة إن النمو في الربع الأول قد ينخفض بواقع نقطة مئوية كاملة ليصل معدله إلى خمسة في المائة أو أقل.
واعترف رئيس مجلس الاحتياطي الفيدرالي (البنك المركزي الأميركي) جيروم باول بخطر وقوع تباطؤ في الصين في الأمد القصير بسبب الفيروس، بما في ذلك الولايات المتحدة، وذلك في مؤتمر صحافي أعقب قرار البنك الذي كان متوقعا على نطاق واسع بالإبقاء على أسعار الفائدة دون تغيير. وذلك من دون أن يشير إلى ما أثاره الخبراء حول قدرات الصين الوفاء بتعهدات اتفاق التجارة الأولي.
ويشار إلى أن بنك الاستثمار الدولي «نومورا» قد حذر من أن تداعيات «كورونا الجديد» على الاقتصاد الصيني قد تفوق في خطورتها تلك التي أحدثها وباء «سارس» الذي ضرب البلاد في الفترة ما بين عامي 2002 و2004، وتوقع أن يتراجع الناتج المحلي الإجمالي للصين في الربع الأول من 2020 بنسبة قد تتعدى 2 في المائة، أي أعلى من معدل الانخفاض الذي تسبب به وباء «سارس» في الربع الثاني من عام 2003.
وأوقفت شركات طيران رحلاتها إلى الصين ومنها بريتيش إيروايز ولوفتهانزا وإير كندا وأميركان إيرلاينز، كما علقت شركة العال الإسرائيلية رحلاتها حتى مارس (آذار).
ويتزايد القلق من أن يواجه آلاف من عمال المصانع بالصين صعوبة في العودة إلى عملهم الأسبوع القادم بعد انقضاء عطلة السنة القمرية الجديدة بسبب القيود على الحركة والانتقال الرامية لمنع انتشار الفيروس.
وانضمت شركة غوغل التابعة لألفابت، وشركة إيكيا السويدية لشركات كبرى أوقفت عملياتها بالصين، كما اتسعت قائمة الأحداث الرياضية المتضررة إذ أرجأ الاتحاد الصيني لكرة القدم المباريات المحلية في 2020 وتحيط الشكوك بمباريات التصفيات المؤهلة للأولمبياد في أستراليا مع عزل فريق الصين لكرة القدم النسائية بفندق في برزبين.
وقالت صحيفة «نيويورك تايمز» الأربعاء إن تفشي فيروس كورونا الجديد يختبر مدى اعتماد العالم على الصين. وأوضحت أن فيروس كورونا أدى إلى تعطيل أحد أهم محركات النمو في العالم، حيث قامت السلطات الصينية، عقب محاولات فاشلة في إبطاء وتيرة تفشي الفيروس، بتمديد عطلة رأس السنة الصينية حتى 3 فبراير المقبل، كما عَطّلت حركة النقل الجوي والبري والنقل عبر السكك الحديدية، وأغلقت كافة المدن لديها.
وأشارت الصحيفة إلى أن الصين أصبحت جزءا أساسيا من آلة الصناعة العالمية الحديثة بعد أن كانت أمة فقيرة منذ أربعة عقود، فالصين وحدها مسؤولة عن نحو سدس الناتج الاقتصادي العالمي، وتعد أكبر صانعة ومتاجرة في العالم.
وقال جيك باركر، نائب رئيس مجلس الأعمال الأميركي - الصيني، إن أعضاء المجلس يتعرضون لدرجات متفاوتة من الاضطراب في أعمالهم التجارية، بما في ذلك مشاكل سلاسل التوريد والإغلاق المؤقت لبعض المصانع ومنافذ البيع بالتجزئة، فضلاً عن مواجهتهم تحديات أخرى. وأوضح أنه إذا تم تمديد حظر السفر أو الحجر الصحي أو عطلة رأس السنة الصينية لفترة تتجاوز 8 فبراير المقبل، سيتسبب ذلك في مضاعفة هذه المشكلات.
من جهتها، قالت منظمة السياحة العالمية، بحسب الصحيفة، إن المستهلكين في الصين يشترون السيارات والهواتف الذكية بدرجة تفوق أي بلد آخر، كما ينفق السائحون الصينيون 258 مليار دولار في العام ما يقارب ضعف ما ينفقه الأميركيون. ولفتت الصحيفة إلى أن مدينة ووهان الصينية التي انطلق منها الفيروس تعد أحد أكبر مراكز النقل الوطنية في الصين وتحوي متاجر لشركات سيارات كبرى مثل «هوندا» و«نيسان»، كما تعد المدينة مركزا لأكثر من ثلث الاستثمارات الفرنسية في الصين.
وقالت «بلومبرغ»، إن الجيران الآسيويين ومصدري السلع، سيواجهون أكبر ضربة من تفشى الفيروس المميت في الصين. وقال راجيف بيسواس، كبير الاقتصاديين في منطقة آسيا والمحيط الهادي لدى «آي إتش إس ماركيت»، إن فيروس كورونا يشكل خطراً سلبياً كبيراً على المستقبل الاقتصادي لآسيا والمحيط الهادي على المدى القريب في 2020، إذا استمر الوباء في التصاعد خلال الأسابيع المقبلة.
وأضاف «سيتوقف مدى وقوة تأثير هذه الصدمة السلبية للنمو الاقتصادي الإقليمي، على مدى سرعة السيطرة على وباء الفيروس».
وكانت مقاطعة ووهان، تلقت أعنف الضربات الاقتصادية، إذ تم إغلاق المدينة التي يبلغ عدد سكانها 11 مليون نسمة، في محاولة لوقف انتشار الفيروس، تاركة الطرق خالية وملايين الناس معزولين. وأوضحت «بلومبرغ» أن اقتصاد المدينة البالغ 214 مليار دولار، يشكل نحو 1.6 في المائة من الناتج المحلي الإجمالي الوطني، إذ إنها مركز حيوي لصناعة الخدمات اللوجيستية والسيارات والصلب وسط الصين، مما يضخّم تأثير الاضطرابات على السفر والإنتاج هناك.
وقال شون روش، كبير الاقتصاديين في منطقة آسيا والمحيط الهادي في وكالة «ستاندرد آند بورز»، إن سلاسل التوريد المعقدة والإنتاج، قد تعني أن انقطاع الإنتاج في مصانع ووهان، ستكون له آثار مباشرة وكبير.
وإلى جانب الحجر الصحي في ووهان، وأجزاء أخرى من مقاطعة هوبي، مددت الصين العطلة الحالية بضعة أيام، وطلبت مقاطعات أخرى منها شنغهاي من الشركات تأجيل إعادة فتح أبوابها لمدة أسبوع آخر. وأشارت «بلومبرغ» إلى أن هذا الإغلاق المطول سيؤثر على دخل الشركات الصينية، ويضر بالاستهلاك ويقلل أيضاً من الإنتاج والصادرات الصناعية.
«كورونا» يهدد تعهدات اتفاق التجارة الصيني ـ الأميركي... والأنظار على «المادة 7»
توقعات متزايدة بهزة اقتصادية عنيفة

باحث داخل معمل للأحياء الدقيقة وعلوم الفيروسات في ميلانو بإيطاليا (إ.ب.أ)

«كورونا» يهدد تعهدات اتفاق التجارة الصيني ـ الأميركي... والأنظار على «المادة 7»
باحث داخل معمل للأحياء الدقيقة وعلوم الفيروسات في ميلانو بإيطاليا (إ.ب.أ)
لم تشترك بعد
انشئ حساباً خاصاً بك لتحصل على أخبار مخصصة لك ولتتمتع بخاصية حفظ المقالات وتتلقى نشراتنا البريدية المتنوعة




















